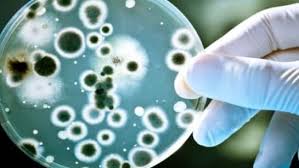

പകർച്ചവ്യാധികൾ കവർന്നത് സംസ്ഥാനത്ത് 451 ജീവനുകൾ; എലിപ്പനി ബാധിച്ച് മാത്രം 180 മരണം
എലിപ്പനി, ഡെങ്കിപ്പനിയട ക്കമുള്ള പകർച്ചവ്യാധികൾ ബാധി ച്ച് സംസ്ഥാനത്ത് ഈ വർഷം ഇതു വരെ മരിച്ചത് 451 പേർ. ആരോഗ്യവ കുപ്പിന്റെ നവംബർ അഞ്ചുവരെയു ള്ള കണക്കുപ്രകാരമാണിത്. കൂടു തൽ പേർക്ക് ജീവഹാനി സംഭവിച്ച ത് എലിപ്പനി ബാധിച്ചാണ് 180 പേർ. 2911 പേർക്കാണ് രോഗബാധ സ്ഥിരീ കരിച്ചത്. അമീബിക് മസ്തിഷ്കജ്വരം 161 പേർക്കാണ് സ്ഥിരീകരിച്ചത്. ഇതിൽ 37 പേർ മരിച്ചു. ഉറവിടം സംബന്ധി ച്ച് പഠനം നടത്തുമെന്ന് ആരോഗ്യവ കുപ്പ് അറിയിച്ചിരുന്നെങ്കിലും തുടർ നടപടികളൊന്നുമായില്ല. ഹെപ്പറ്റൈ റ്റിസ് എ ബാധിച്ച് 61 പേരും ഇൻ
വൻസ മൂലം 41 പേരും പനി ബാധിച്ച് 17 പേരും ഈ കാലയളവിൽ മരിച്ചു.
പേവിഷബാധ സ്ഥിരീകരിച്ച 25 പേർക്കും ജീവഹാനിയുണ്ടായി. ചെ ള്ളുപനി മൂലം 13 പേർ മരിച്ചപ്പോൾ ഡെങ്കിപ്പനി കവർന്നത് 42 പേരുടെ ജീവനാണ്. 9720 പേർക്കാണ് ഡെ ങ്കിപ്പനി സ്ഥിരീകരിച്ചിരുന്നത്. നാലു പേർക്ക് നിപ ബാധിച്ചതിൽ രണ്ടു പേർ മരിച്ചു. ചിക്കൻപോക്സ് ബാധി ച്ച് എട്ടുപേരും എ.ഡി.ഡി മൂലം ഒമ്പ തു പേരും എ.ഇ.എസ് ബാധിച്ച് 13 പേരും മലേറിയ മൂലം രണ്ടുപേരും കോളറ മൂലം ഒരാളും മരിച്ചു.
ഒക്ടോബറിൽ മാത്രം സംസ്ഥാന ത്ത് മരിച്ചത് 46 പേരാണ്. എലിപ്പ നിമൂലം 15 പേരും അമീബിക് മസ്തി ഷ്ക ജ്വരം ബാധിച്ച് 12 പേരും മരിച്ചു. 326 പേർക്കാണ് ഒക്ടോബറിൽ എലി പനി സ്ഥിരീകരിച്ചിരുന്നത്. ഈ മാ സത്തിൽ അമീബിക് മസ്തിഷ്ക ജ്വ
രം സ്ഥിരീകരിച്ചത് 65 പേർക്കാണ്. ചിലർ രോഗമുക്തി നേടിയെങ്കിലും പല കേസുകളിലും രോഗബാധയു ടെ ഉറവിടം കണ്ടെത്താൻ സാധി ക്കാത്തത് ഭീതിയുയർത്തുന്നുണ്ട്. എല്ലാതരം ജലസ്രോതസ്സുകളിൽ നി ന്നും വെള്ളം ഉപയോഗിക്കുമ്പോൾ അതീവ ശ്രദ്ധ പുലർത്തേണ്ട സ്ഥി തിയാണ്. ഡെങ്കിപ്പനി ബാധിച്ച് ഏഴു പേരും പനിമൂലം അഞ്ചുപേരും മരി ച്ചു. ചിക്കൻപോക്സ് രണ്ടുപേരുടെ ജീവനെടുത്തു.
ഹെപ്പറ്റൈറ്റിസ് എ, ഇൻഫ്ലുവൻ സ, ചെള്ളുപനി, പേവിഷബാധ, എ.ഇ.എസ് എന്നിവ മൂലം അഞ്ചു പേർ മരിച്ചു. ആഗസ്റ്റിൽ 32 പേരും സെപ്റ്റംബറിൽ 35 പേരുമാണ് എലി പനി ബാധിച്ച് മരിച്ചത്. ഒക്ടോബറിൽ ഇത് പകുതിയോളം കുറഞ്ഞതാണ് ആശ്വാസം. സെപ്റ്റംബറിൽ 11 പേരാ ണ് മസ്തിഷ്കജ്വരം മൂലം മരിച്ചത്.

